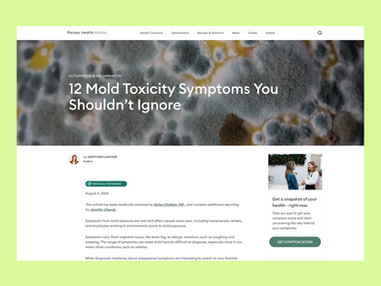

TRUSTED BY
How We Work
We’re the content team you’d build in-house... if you had unlimited time, budget, and access to the best people in health.
01
We're Experts at Health & Healthcare
We work exclusively in health and exclusively with its best talent. Strategy, writing, editing, design, SEO, GEO/AEO, CRO, you name it—everything's handled by an experienced team that knows credibility is table stakes in this space.
02
We Lead With Humans, Optimize for AI
Every asset we create is expert-written and rigorously reviewed by humans. Then, it's optimized to dominate traditional and generative AI search.
We don't just keep up with the new landscape, we take pride in creating it.
03
We Partner Selectively, Then Go Deep
We don’t take on every project.
We partner with health brands that see content as a strategic advantage, not a box to check. Ultimately, we make content central to how your company shows up, earns trust, and wins.
04
We Scale With Intention
We treat content as a compounding asset, not a one-off deliverable. That means we track performance, double down on what works, evolve what doesn't, and expand strategically—turning early traction into sustainable, long-term growth.
Health content deserves better. We aim to build the accuracy, authority, and performance standard for the industry.
Our Services
Everything health brands need to turn content into a competitive advantage.
.png)
Content Strategy
A clear, insight-driven roadmap that tells you what to create, why it matters, and how it drives growth. We align your brand, audience needs, and search opportunity into a plan built for results.
%20copy.png)
Technical SEO & GEO
We strengthen your technical foundation and optimize for the new era of AI-driven search. From crawlability and schema to GEO experimentation, we make sure your content is discoverable, competitive, and surfaced where your audience is looking.
.png)
CRO
Turn traffic into meaningful action. We audit your funnels, messaging, and UX to uncover friction—then test and refine to improve conversions across landing pages, articles, and patient/customer journeys.
%20copy%202.png)
Editorial Engine
Expert-led, deeply researched content your audience (and search engines) can trust. Built for accuracy, authority, and ranking power, we write "best answer on the Internet" articles that establish category leadership AND drive conversion at the same time.
%20copy.png)
Authority Building
Grow your brand's credibility with our unique program that generates links, citations, and mentions (great for LLMs) through proactive and reactive outreach to journalists—powered by your clinician quotes and expertise.
%20copy%203.png)
AI Visibility Editorial
Expert-written content engineered to be recognized, cited, and recommended by ChatGPT and other LLMs. We help you gain visibility by winning at the prompts that matter most in a place where competition has never been more open.
%20copy%204.png)
Newsletters & Email
Consistent, high-quality communication that drives loyalty and action. We help you stay top-of-mind with messaging that educates, engages, and converts through newsletters, lifecycle marketing copy, etc.
.png)
White Papers / Reports
High-signal, deeply researched assets that educate, persuade, and convert. Ideal for demand generation, partnership conversations, and establishing thought leadership in complex or regulated spaces.
.png)
Case Studies
Proof that builds trust fast. We turn your wins into compelling stories that show measurable impact—making it easier for prospects to see themselves succeeding with you.
.png)
Copywriting & Landing Pages
Clear, persuasive messaging built to move people through the funnel. We blend conversion psychology, brand voice, customer empathy, and deep expertise to create pages that resonate deeply and drive action.
.png)
Blog Refreshes
Unlock hidden performance. We update outdated or underperforming content with new insights, structure, and optimization—helping you reclaim rankings, improve accuracy, rank in LLMs, and capture more demand.
Testimonials

Joanna Strober
CEO & Co-Founder, Midi
"We couldn't have grown this critical content channel better than with Healthyish & Derek. Thanks to their unique and high quality approach, we've seen content & SEO become a major source of traffic and conversion in far shorter time than we even expected."

Stephen Smith
CEO & Co-Founder, NOCD
"NOCD significantly benefited from Derek & his team at Healthyish. They played a key role in supporting the build-out of NOCD’s content strategy and team, which helped us diversify our enrolment channels and drop acquisition cost year over year."

Zachariah Reitano
Co-Founder & CEO, Ro
"Derek and the Healthyish Content team are just the best at content and SEO. Smart, strategic, fast, and super easy to work with—our whole team loved collaborating with them. Plus, their articles were successful and converted. Can’t recommend them highly enough"
Expert Talent
The Health Content Team Behind the Internet’s Most Trusted Brands
Healthyish Content is a hand-picked team of best-in-class experts—editors, writers, SEO/GEO strategists, designers, and more. We bring the same talent behind Healthline, Greatist, GoodRx, Midi, and Ro to your brand. Plus, every team is custom tailored for each client's needs, delivering the perfect premium talent without the overhead.

Saralyn Ward
Editorial Partner
Saralyn Ward, is an award-winning writer and former Senior Editor at Healthline, where she launched the brand’s fitness content across web and YouTube. She’s also the founder of the Better After Baby app and content lead for the U.S. Air Force’s Fit Warrior Mom program. Her work has appeared in TODAY Parents, Thrive Global, and Scary Mommy.

Sarah McNaughton
SEO Partner
Sarah is an award-winning SEO and content strategy expert with more than a decade of experience at top health and lifestyle publications, including LIVESTRONG.com, Hearst Magazines, and Everyday Health. She’s passionate about making online health information more trustworthy, helpful, and accessible.
In Action
See examples of what we do below:
Resources
Clear, expert-led guidance on what’s working in health content, SEO, and AI-driven discovery.